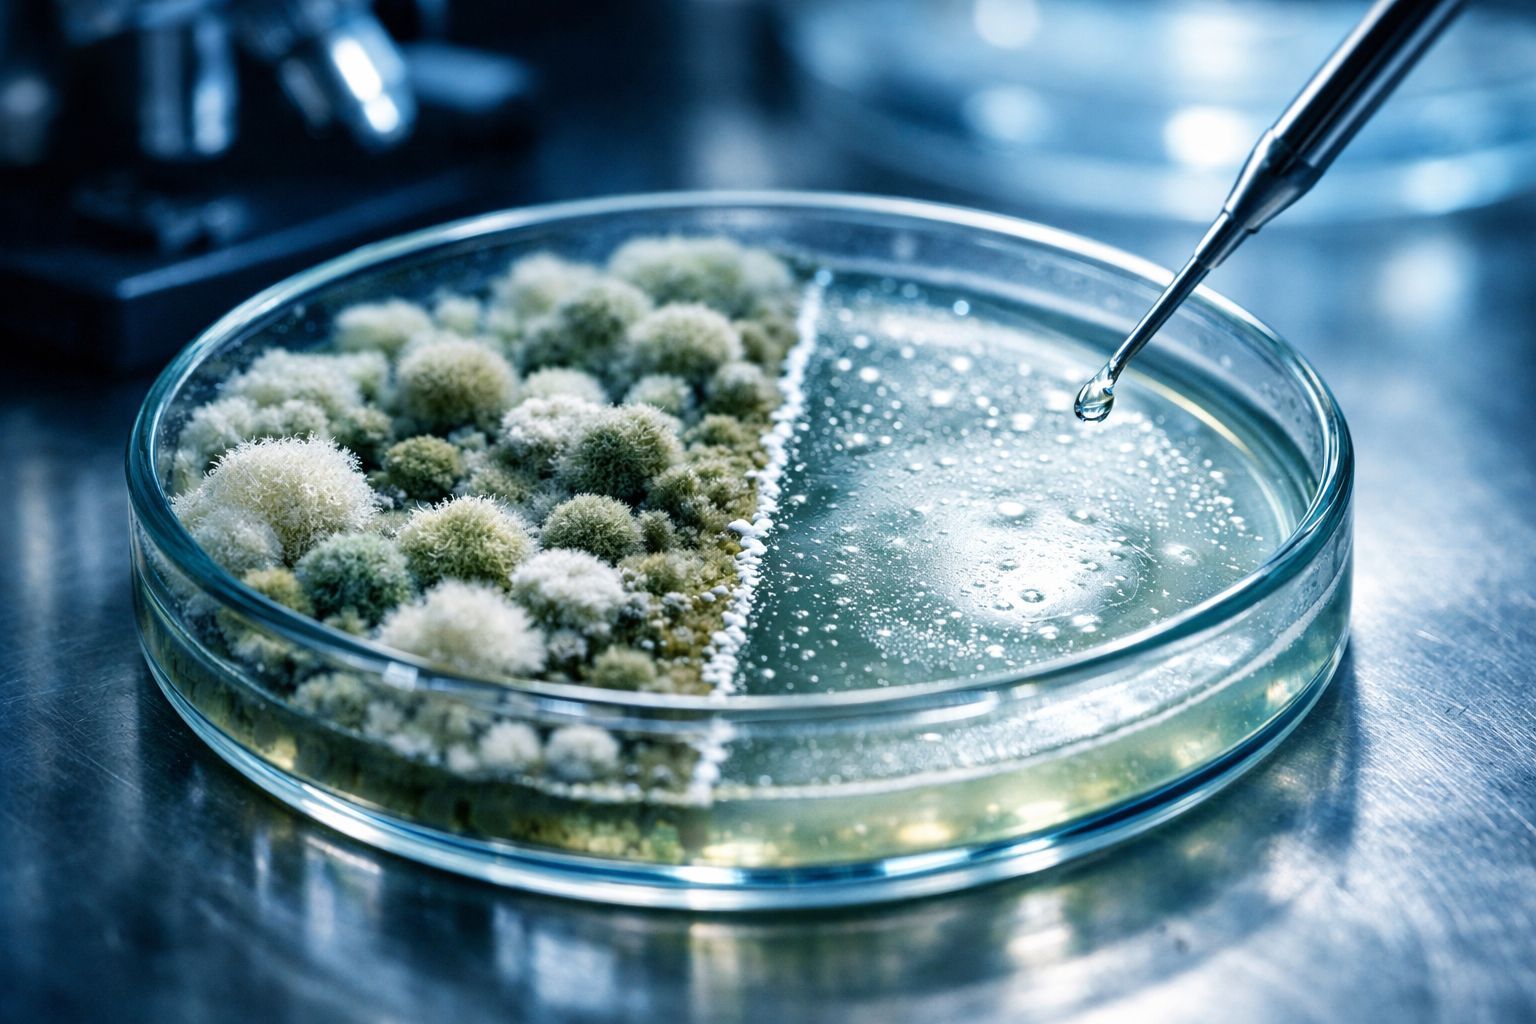

Une protéine sanguine commune serait notre meilleur bouclier contre le redoutable « champignon noir »
Auteur: Mathieu Gagnon
Un gardien inattendu dans notre sang

On entend souvent parler des globules blancs comme des soldats de notre immunité, mais il semblerait que nous ayons sous-estimé un autre acteur majeur, bien plus discret. L’albumine, vous en avez sûrement déjà entendu parler lors d’une prise de sang, n’est-ce pas ? C’est la protéine la plus courante dans notre circulation sanguine. Produite par le foie, on la connaissait surtout pour son rôle de « taxi » transportant hormones et protéines, ou pour sa capacité à maintenir l’équilibre des fluides dans notre corps.
Mais voilà qu’une nouvelle étude, tout juste publiée dans la prestigieuse revue Nature, vient bousculer nos certitudes. Pour la toute première fois, des chercheurs ont démontré que cette molécule joue un rôle direct, et vital, dans la lutte contre un pathogène particulièrement agressif : la mucormycose, souvent surnommée le « champignon noir ». C’est fascinant de voir comment notre corps recèle encore des mécanismes de défense que nous ignorions totalement jusqu’ici.
Une « mauvaise herbe » mortelle et un constat troublant

Il faut dire que l’ennemi en question n’est pas à prendre à la légère. La mucormycose est une infection fongique rare mais d’une sévérité extrême. Imaginez une sorte de mauvaise herbe invasive qui s’infiltrerait dans vos vaisseaux sanguins pour nécroser les tissus ; c’est exactement ainsi qu’elle agit. Elle s’attaque de préférence aux personnes dont le système immunitaire est déjà fragilisé ou, très souvent, aux patients diabétiques.
Les chiffres font froid dans le dos : plus de 50 % des personnes diagnostiquées avec cette mucormycose ne survivent pas. C’est brutal. Pour essayer de comprendre pourquoi ce champignon s’acharne sur les patients ayant des problèmes métaboliques, les chercheurs ont dû éplucher les données cliniques de centaines de malades. Et c’est là, en fouillant dans les dossiers, qu’un détail a attiré leur attention.
Ils ont remarqué une coïncidence qui ne pouvait pas être due au hasard : les patients qui décédaient de l’infection présentaient presque systématiquement des niveaux très bas d’albumine. Tiens donc… D’ailleurs, des recherches antérieures avaient déjà fait le lien entre un manque d’albumine et un taux de survie plus faible face à d’autres infections. Il y avait là une piste sérieuse à creuser.
L’expérience décisive et le mécanisme de défense
Pour en avoir le cœur net, l’équipe scientifique a décidé de passer de l’observation à l’action en laboratoire. Ils ont conçu une expérience assez simple sur le papier, mais révélatrice. Ils ont pris du sang sain et en ont retiré l’albumine. Le résultat ? Dès qu’ils ont introduit le champignon dans ces échantillons appauvris, celui-ci a proliféré de manière totalement incontrôlée. Une véritable invasion. À l’inverse, lorsqu’ils ont restauré les niveaux d’albumine, la progression du pathogène a été stoppée net. C’est assez incroyable, non ?
Mais comment une simple protéine de transport peut-elle faire ça ? Les scientifiques se sont penchés sur la structure même de la molécule. Ils ont découvert que l’albumine possède des sortes de « poches » capables de se lier aux acides gras. C’est ici que la magie opère : lorsque l’albumine rencontre le champignon, elle libère ces graisses protectrices. Ces dernières empêchent alors le champignon de produire de la mucoricine, une toxine redoutable qui détruit les tissus humains.
C’est une découverte fondamentale. Comme le précise l’étude (créditée Nature 2026, DOI: 10.1038/s41586-025-09882-3), une carence en albumine compromet la composition des acides gras libres (FFA) du sérum, ouvrant ainsi la porte à l’infection.
Conclusion : Vers de nouveaux espoirs thérapeutiques

Alors, que peut-on espérer pour l’avenir des patients ? Cette découverte pourrait bien changer la donne dans la manière dont nous détectons et traitons cette maladie. Georgios Chamilos, l’auteur principal de l’étude, ne cache pas son enthousiasme : « Nos résultats révèlent un rôle régulateur maître de l’albumine dans la défense de l’hôte contre les Mucorales [l’ordre de champignons incluant les espèces causant la mucormycose], suggérant que corriger l’hypoalbuminémie pourrait être une stratégie simple et efficace pour prévenir et traiter la mucormycose. »
Concrètement, cela signifie que nous pourrions bientôt utiliser un simple test du taux d’albumine comme système d’alerte précoce pour repérer les personnes à risque. Et pour le traitement ? Si développer de nouvelles thérapies ciblées prendra du temps, une solution bien plus immédiate et praticable se dessine : administrer des suppléments d’albumine aux individus fragiles pour restaurer leurs défenses naturelles. Parfois, les solutions les plus efficaces sont celles qui aident simplement notre corps à faire ce qu’il sait faire de mieux.
Selon la source : medicalxpress.com
Ce contenu a été créé avec l’aide de l’IA.